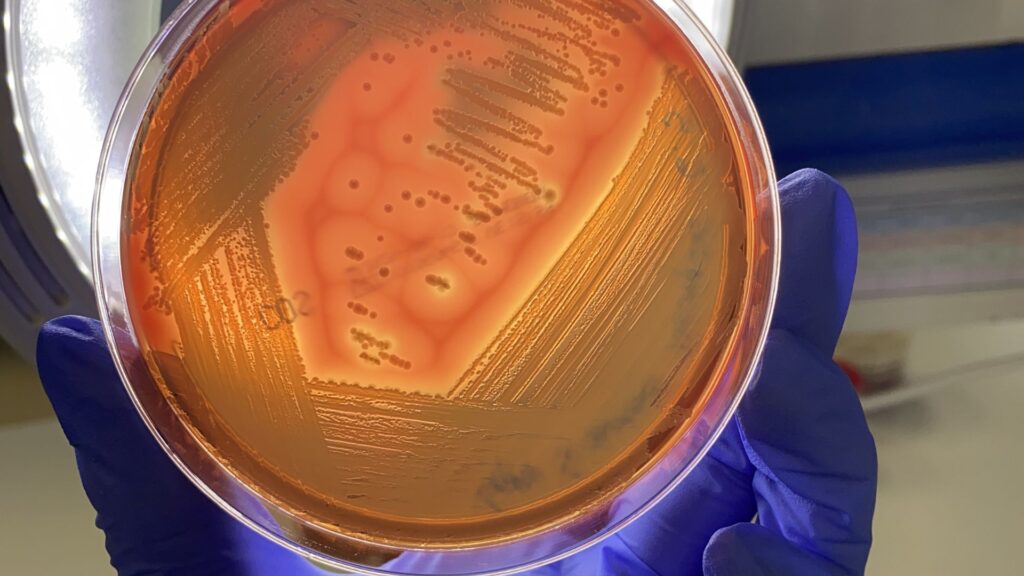
diseño sin título (27)

BLOG ANALÍTICA VETERINARIA
Melanoma maligno hepático
En este caso clínico de melanoma maligno hepático en una cabra revisamos las lesiones macroscópicas observadas en el hígado, las pruebas diagnósticas realizadas y los hallazgos histopatológicos que permitieron confirmar el diagnóstico definitivo.
APP de Analítica Veterinaria
Gestiona tus análisis laboratoriales de forma rápida y sencilla con la APP de Analítica Veterinaria. Solicita análisis online, consulta protocolos de muestreo, accede al catálogo actualizado y organiza recogidas de muestras directamente desde la aplicación.
Abortos en pequeños rumiantes
El diagnóstico de abortos en pequeños rumiantes depende en gran medida de la correcta selección y envío de muestras al laboratorio. En este artículo repasamos las principales claves diagnósticas, las muestras más recomendadas y los agentes infecciosos más frecuentemente implicados.
Leche de tanque: tanto con tan poco
La leche de tanque permite obtener información sanitaria del rebaño mediante una única muestra representativa. En este artículo repasamos su utilidad en la detección de patógenos mamarios, el control higiénico y la monitorización de enfermedades en explotaciones de vacuno lechero.
Chlamydia abortus
Chlamydia abortus es un agente asociado a abortos en pequeños rumiantes, especialmente en el último tercio de gestación. En esta infografía resumimos los signos más frecuentes, las lesiones características y las principales técnicas diagnósticas utilizadas para su detección en laboratorio.
Diagnóstico respiratorio en rumiantes
En este protocolo revisamos las principales causas infecciosas de procesos respiratorios en rumiantes, las muestras de elección y las técnicas laboratoriales utilizadas para detectar bacterias, virus y parásitos implicados en patologías respiratorias.
Testaje de sementales
En este protocolo revisamos la recogida de muestras prepuciales y las técnicas utilizadas para la detección de Campylobacter fetus venerealis y Tritrichomonas foetus en toros destinados a reproducción.
Diagnóstico de abortos en vacuno
En este protocolo revisamos las principales causas infecciosas de aborto en vacuno, las muestras de elección y las técnicas laboratoriales utilizadas para detectar agentes bacterianos, víricos y parasitarios implicados en los procesos abortivos bovinos.
Músculo blanco
En este caso clínico de músculo blanco revisamos las lesiones musculares observadas, los hallazgos histopatológicos y la asociación con neumonía por Mannheimia haemolytica en un cordero.
Diagnóstico respiratorio en porcino
En este protocolo revisamos las principales causas infecciosas de procesos respiratorios en porcino, las muestras de elección y las técnicas laboratoriales utilizadas para detectar los agentes implicados en el Complejo Respiratorio Porcino.
Onfalitis y enteritis hemorrágica
En este caso clínico de onfalitis y enteritis hemorrágica revisamos las lesiones observadas durante la necropsia, los hallazgos microbiológicos y la detección de Clostridium perfringens asociada al proceso digestivo en un cabrito.
Diagnóstico digestivo en porcino
En este protocolo revisamos las principales causas infecciosas de procesos digestivos en porcino, las muestras de elección y las técnicas laboratoriales utilizadas para detectar bacterias, virus y parásitos implicados en diarreas y enteropatías porcinas.
Dermatitis exudativa por S. aureus
En este caso clínico de dermatitis exudativa por Staphylococcus aureus revisamos las lesiones cutáneas observadas, el aislamiento bacteriano y los resultados del antibiograma utilizados para orientar el tratamiento del proceso.
Diagnóstico de mamitis en rumiantes
En este protocolo revisamos las principales causas infecciosas de mamitis en rumiantes, la correcta recogida de muestras y las técnicas laboratoriales utilizadas para identificar los patógenos implicados en procesos mamarios clínicos y subclínicos.
Trastornos entéricos en porcino
Los trastornos entéricos en porcino pueden estar asociados a múltiples agentes infecciosos con signos clínicos similares. En este artículo repasamos las muestras más adecuadas para el diagnóstico, las lesiones más frecuentes y las principales técnicas laboratoriales utilizadas en el estudio de procesos digestivos porcinos.
Cenurosis en ovino
La cenurosis en ovinos es una enfermedad parasitaria del sistema nervioso central causada por la fase larvaria de Taenia multiceps, capaz de provocar graves alteraciones neurológicas. Los animales afectados pueden presentar movimientos en círculos, ataxia, ceguera o postración debido a la formación de quistes en el cerebro.
PRRS
El PRRS es una enfermedad vírica del porcino asociada a problemas reproductivos y respiratorios. En esta ficha clínica resumimos los signos más habituales, las principales vías de transmisión y las técnicas diagnósticas utilizadas para la detección del virus en laboratorio.
Coccidiosis caprina
En este caso clínico de coccidiosis caprina revisamos las lesiones intestinales observadas, los hallazgos microscópicos y la detección masiva de coccidios mediante técnicas coproparasitológicas utilizadas para el diagnóstico del proceso digestivo.
Vigilancia no invasiva en porcino
La vigilancia sanitaria en porcino incorpora cada vez más técnicas de muestreo no invasivas como fluidos orales, líquidos de procesado o toallitas ambientales. En este artículo repasamos las principales muestras utilizadas y su aplicación en la detección de enfermedades víricas en granja.
Neumonía por Mannheimia haemolytica
En este caso clínico de neumonía y pleuritis fibrinosa por Mannheimia haemolytica revisamos las lesiones pulmonares observadas, el aislamiento bacteriano y los resultados del antibiograma utilizados para orientar el tratamiento del proceso respiratorio.
Streptococcus suis
Streptococcus suis es una bacteria asociada a meningitis, artritis, septicemia y neumonía en porcino, especialmente en lechones postdestete. En esta ficha clínica resumimos los signos más habituales, las lesiones características y las principales técnicas diagnósticas utilizadas para su detección en laboratorio.
Diagnóstico de diarreas en terneros
En este protocolo revisamos las principales causas infecciosas de diarrea en terneros, las muestras de elección para el diagnóstico y las técnicas laboratoriales utilizadas para detectar bacterias, virus y parásitos implicados en los procesos digestivos neonatales.
Abortos infecciosos en cerdas
Los abortos en cerdas pueden estar asociados a numerosos agentes infecciosos de origen vírico, bacteriano y parasitario. En este artículo repasamos las principales causas implicadas, las muestras más adecuadas para el diagnóstico y las técnicas laboratoriales utilizadas para identificar el agente causal.
Tuberculosis caprina
En este caso clínico de tuberculosis caprina revisamos las lesiones pulmonares observadas, los hallazgos histopatológicos y la detección de micobacterias mediante tinciones específicas. Además, repasamos las principales claves diagnósticas de esta infección en explotaciones caprinas.
Erisipela porcina
La erisipela porcina es una enfermedad bacteriana causada por Erysipelothrix rhusiopathiae, asociada a cuadros septicémicos, artritis y lesiones cutáneas. En esta ficha clínica resumimos los signos más habituales, las lesiones características y las principales técnicas diagnósticas utilizadas para su detección en laboratorio.
Neumonía verminosa
La neumonía verminosa es una parasitosis respiratoria causada por nematodos pulmonares que afectan principalmente a pequeños rumiantes y bovinos. En esta ficha clínica resumimos los signos más habituales, las lesiones características y las principales técnicas diagnósticas utilizadas para su detección en laboratorio.
Salmonelosis porcina
La salmonelosis porcina es una enfermedad bacteriana asociada a enteritis, septicemia y problemas productivos en cerdos. En esta ficha clínica resumimos los signos más habituales, las vías de transmisión y las principales técnicas diagnósticas utilizadas para su detección en laboratorio.
Cómo diagnosticar abortos en pequeños rumiantes
En este protocolo revisamos las principales causas infecciosas de aborto en ovino y caprino, las muestras de elección para el diagnóstico y las técnicas laboratoriales utilizadas para detectar agentes bacterianos, víricos y parasitarios implicados en los procesos abortivos.
Paramfistomosis bovina
La paramfistomosis bovina es una parasitosis digestiva causada por trematodos, asociada a diarrea y pérdida de condición corporal. En esta ficha clínica resumimos los signos más habituales, el ciclo parasitario y las principales técnicas diagnósticas utilizadas en laboratorio.
Aborto por Neospora caninum
En este caso clínico de aborto por Neospora caninum revisamos los resultados serológicos y la detección del parásito mediante PCR en tejidos fetales. Además, repasamos las principales claves diagnósticas de la neosporosis bovina.
Pasteurelosis porcina
La pasteurelosis porcina es una enfermedad respiratoria bacteriana asociada principalmente a Pasteurella multocida, frecuente en el Complejo Respiratorio Porcino. En esta ficha clínica resumimos los signos más habituales, las lesiones características y las principales técnicas diagnósticas utilizadas para su detección en laboratorio.
Intoxicación por cobre
La intoxicación por cobre es un proceso tóxico frecuente en ovino, asociado a daño hepático y crisis hemolíticas agudas. En esta ficha clínica resumimos los signos más habituales, las lesiones características y las principales técnicas laboratoriales utilizadas para su diagnóstico.
Cómo diagnosticar abortos en porcino
En este protocolo revisamos las principales causas infecciosas de aborto en porcino, las muestras de elección para el diagnóstico y las técnicas laboratoriales utilizadas para detectar agentes bacterianos, víricos y parasitarios implicados en los fallos reproductivos de las explotaciones porcinas.
Paratuberculosis caprina
La paratuberculosis caprina es una enfermedad intestinal crónica causada por Mycobacterium avium subsp. paratuberculosis (Map). En esta ficha clínica resumimos los signos más frecuentes, las principales vías de transmisión y las técnicas diagnósticas utilizadas para su detección y control en explotaciones caprinas.
Micoplasmosis pulmonar bovina
La micoplasmosis pulmonar bovina es una enfermedad respiratoria asociada principalmente a Mycoplasmopsis bovis, capaz de provocar neumonía crónica y brotes respiratorios en terneros. En esta ficha clínica resumimos los signos más habituales, las lesiones características y las principales técnicas diagnósticas utilizadas en laboratorio.
Aborto por Virus Border
En este caso clínico de aborto por Virus Border revisamos las malformaciones fetales observadas, la detección del antígeno viral y los resultados serológicos asociados. Además, repasamos las principales claves diagnósticas y epidemiológicas de esta infección en pequeños rumiantes.
Diarrea Epidémica Porcina (DEP)
La Diarrea Epidémica Porcina (DEP) es una enfermedad vírica entérica que afecta principalmente a lechones lactantes, causando diarrea y deshidratación. En esta ficha clínica resumimos los signos más frecuentes, las vías de transmisión y las principales técnicas diagnósticas utilizadas para su detección en laboratorio.
Adenocarcinoma Nasal Enzoótico (ANE)
El Adenocarcinoma Nasal Enzoótico (ANE) es un tumor respiratorio contagioso que afecta principalmente a ovejas y cabras. En esta ficha clínica resumimos los signos más habituales, las lesiones características y las principales herramientas diagnósticas utilizadas para su detección en pequeños rumiantes.
Aborto por Toxoplasma gondii
En este caso clínico de aborto por Toxoplasma gondii revisamos las lesiones placentarias más características, los resultados serológicos y la detección del parásito mediante PCR. Además, repasamos las claves diagnósticas y epidemiológicas de la toxoplasmosis en pequeños rumiantes.
Criptosporidiosis ovina
La criptosporidiosis ovina es una parasitosis intestinal frecuente en corderos jóvenes, asociada a diarrea neonatal y deshidratación. En esta ficha clínica resumimos los signos más habituales, las vías de transmisión y las principales técnicas diagnósticas utilizadas para su detección en laboratorio.
Brucelosis porcina
La brucelosis porcina es una enfermedad bacteriana asociada a abortos, infertilidad y problemas reproductivos en cerdos. En esta ficha clínica resumimos los signos más frecuentes, las vías de transmisión y las principales técnicas diagnósticas utilizadas para su detección y control en laboratorio.
Aborto por Chlamydia abortus
En este caso clínico de aborto por Chlamydia abortus revisamos las lesiones placentarias más características, la observación microscópica de cuerpos clamidiales y la detección del patógeno mediante PCR. Además, repasamos las principales claves diagnósticas del aborto enzoótico en pequeños rumiantes.
Enfermedad Hemorrágica Epizoótica (EHE)
La Enfermedad Hemorrágica Epizoótica (EHE) se ha convertido en una preocupación creciente para el sector ganadero, especialmente en explotaciones de vacuno. Conocer sus síntomas, vías de transmisión, métodos de diagnóstico y estrategias de prevención es fundamental para reducir su impacto sanitario y productivo.
Seroperfiles reproductivos en el ganado vacuno
Los seroperfiles reproductivos en ganado vacuno son una herramienta fundamental en el diagnóstico de abortos e infertilidad, pero su diseño e interpretación requieren criterio epidemiológico. Repasamos cómo planificar el muestreo, qué pruebas incluir y cómo estimar prevalencias para tomar decisiones sanitarias acertadas en el rebaño.
ELISA en rumiantes: fundamentos para interpretar la serología
La técnica ELISA es una herramienta básica en el control sanitario de rumiantes, pero su interpretación no siempre es sencilla. Repasamos cómo funciona, qué significan sensibilidad y especificidad y cómo afectan los valores predictivos a la toma de decisiones en campo.
¿Existe realmente microbiota en la ubre?
En los últimos años se ha cuestionado la idea de que la glándula mamaria sana sea estéril, apoyándose en estudios de ADN bacteriano en leche “normal”. Rainard revisa críticamente esta hipótesis y concluye que choca con lo que sabemos del sistema inmune mamario y de la patogenia de las mastitis.
Mamitis en rumiantes lecheros: revisión etiológica
Estudios en caprino, ovino y bovino lechero, basados en más de 90.000 muestras de leche, muestran qué patógenos predominan en mamitis clínicas y subclínicas y cómo mejorar el diagnóstico y el control en granja.